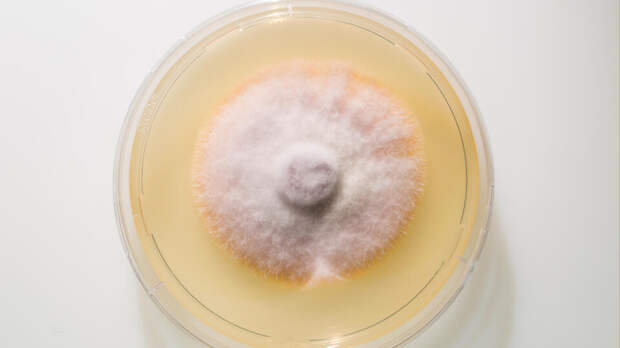

www.globallookpress.com/Klaus-Dietmar Gabbert
www.globallookpress.com/Klaus-Dietmar Gabbert Опасная грибковая инфекция, которую уже называют "супергрибком", стремительно распространяется по Европе. Об этом 25 ноября сообщает Daily Star.
Новый штамм Trichophyton indotineae устойчив к обычным лекарствам, вызывает сильные высыпания и чаще всего поражает паховую область и ягодицы.
За последние три года число заболевших выросло примерно на 500%.Эта инфекция легко передается: достаточно прямого контакта с зараженным человеком. Подхватить грибок можно как, например, во время секса, так и через вещи и поверхности, с которыми контактировал инфицированный. И самое неприятное – многие препараты на нее просто не действуют, поэтому высыпания держатся неделями и трудно поддаются лечению.
Обычно болезнь начинает проявляться в виде кольцевидных пятен в паху или на ягодицах, которые затем распространяются по всему телу. По сути, это тяжелая разновидность лишая, знакомого медицине много веков, но его современный штамм стал куда опаснее и устойчивее.
Специалист по грибковым инфекциям из Имперского колледжа Лондона профессор Дариус Армстронг-Джеймс рассказал, что рост заболеваемости вызывает серьезную тревогу, особенно учитывая, как редко эта инфекция встречалась еще несколько лет назад.
Отмечается, что почти три четверти обследуемых пациентов из Британии в последнее время не выезжали за границу – то есть грибок уже активно передается внутри страны. Случаи заражения данным штаммом также уже зафиксировали в США, Франции и Германии.
Ранее, 18 ноября, стало известно, что смертность от устойчивых инфекций выросла на 9%.
РЕН ТВ в мессенджере МАХ – главный по происшествиям
Свежие комментарии